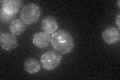
YPR091C
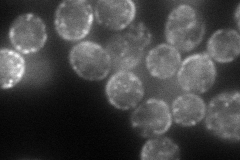
YPR091C
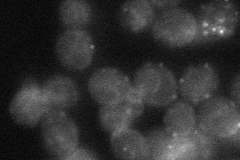
YPR091C
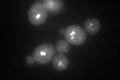
YPR091C
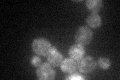
YPR091C

View description
Putative protein of unknown function; may interact with ribosomes, based on co-purification experiments; green fluorescent protein (GFP)-fusion protein localizes to the endoplasmic reticulum; YPR091C is not an essential gene
Localization:
Intensity:
Fold change:
Significance:
-
C’ GFP library in SD
punctate, ER32.88 -
N' NOP1pr-GFP in SD
cell periphery,ER,punctate109.842 -
N' TEF2pr-mCherry in SD

cell periphery,punctate127.31 -
N' NATIVEpr-GFP in SD
cell periphery,ER,punctate30.3479 -
N' TEF2pr-VC and Cyto-VN in SD

below threshold23.7273 -
C’ GFP library in SD+DTT
punctateN/AN/ANo -
C’ GFP library in SD+H2O2
punctate, ER34.791.05No -
C’ GFP library in Starvation Media

punctate, ER35.71.08No -
C’ GFP library on the background of Pup2-DaMP

punctate, ER -
C’ GFP library on the background of CCT mutant

punctate, ER32.74170.995482No
